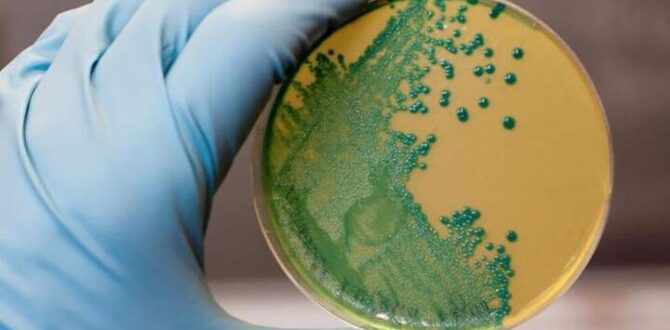

На Дніпропетровщині зафіксовано випадок лістеріозу. Ця інфекція може суттєво нашкодити здоров'ю та призвести навіть до смерті.
У Кривому Розі захворів на лістеріоз у підліток 2013 року народження. Про це повідомляє Криворізький районний відділ Дніпропетровського обласного центру контролю та профілактики хвороб.
З 2017 року в нашому місті випадки захворювання на лістеріоз не реєструвались. В Україні це другий випадок в цьому році, перший випадок зареєстровано в Закарпатській області в березні. В минулому році в Україні в І кварталі зареєстровано 3 випадки захворювань, за 2024, 2023 роки зареєстровано по 12 випадків, в 2022 – лише 2. В 2024 році випадки реєструвались в Волинській області (3), Житомирській (3), Запорізькій (1), Чернігівській (1), Івано-Франківській (1), Київській (1) та м. Київ (1)", – йдеться в повідомленні.
Як можна заразитися та хто в зоні ризику
Лістеріоз — це інфекційне захворювання, спричинене бактеріями Listeria monocytogenes, які живуть у м’ясі, рибі, молоці, овочах і навіть у ґрунті.
"Тварини виділяють лістерії в зовнішнє середовище з випорожненнями, сечею, носовим слизом, молоком, навколоплідною рідиною. Зараження людини відбувається при контакті з інфікованими тваринами та птахами, догляду за ними, вживанні м’ясної чи рибної продукції без термічної обробки (сире молоко, сирокопчені ковбаси, сир, особливо придбаний на стихійних ринках), через овочі і фрукти. Від людини до людини лістерії передаються фекально-оральним шляхом, тому дуже важливо дотримуватись правил гігієни і ретельно мити руки", – йдеться в повідомленні.
Особливо вразливі до нього люди зі слабким імунітетом, діти, літні та вагітні.
Симптоми хвороби
У людей із сильним імунітетом хвороба проявляється, як звичайне отруєння. Через це можуть бути невиявлені випадки, деякі одужують самі, не звертаючись до лікарів, і, відповідно, не роблять аналіз на бактерію.
У тих, хто в зоні ризику, може вразити нервову систему і призвести до менінгіту чи смерті. Може розвиватися інвазивний лістеріоз – це означає, що мікрофлора кишечника не змогла подолати лістерію, і вони поширюються організмом далі.
Симптоми інвазивної форми зазвичай розвиваються через пару тижнів після контакту з збудником, але інкубаційний період може досягати 90 днів:
- збільшені лімфовузли;
- ригідність м'язів шиї (складно зігнути голову);
- біль у попереку;
- хворобливе сечовипускання;
- сплутаність свідомості, судоми, втрата рівноваги.
- Зрештою можуть розвинутися сепсис та запалення мозку (лістеріозний менінгоенцефаліт). Саме вони призводять до смерті.
Чи бувають спалахи
Навіть у високорозвинених країнах таке фіксується регулярно. Найбільший в історії спалах стався в ПАР у 2017—2018 роках: було зареєстровано 1060 підтверджених випадків та 216 смертей. Джерелом зараження стала варена ковбаса місцевого виробника.
Як правило, саме готові до споживання продукти стають причиною таких спалахів. У США 2022-го понад два десятки людей захворіли, поївши морозива. В Італії також у 2021—2022 роках почався спалах через сосиски з м'яса птиці, захворіли як мінімум 90 людей, троє померли.
Як захиститися від лістеріозу
Бактерії Listeria monocytogenes гинуть під час термічної обробки: при 62 °C — за 35 хвилин, при 100 °C — менш ніж за 5 хвилин. Їх також знищують дезінфікуючі засоби, особливо з вмістом хлору.
Повністю убезпечити себе від лістерій складно, адже потенційно вони можуть бути в багатьох продуктах. Проте зменшити ризик зараження можливо:
- купуйте лише якісні продукти без ознак псування або пошкоджень;
- не вживайте прострочену їжу;
- обирайте молочні продукти з пастеризованого молока;
- ретельно мийте овочі та фрукти перед вживанням, особливо якщо їсте їх сирими;
- зберігайте сирі й готові продукти окремо й у герметичних упаковках;
- використовуйте різні дошки та ножі для сирих і приготованих продуктів;
- добре проварюйте або просмажуйте м’ясо, птицю й рибу;
- регулярно мийте холодильник, одразу витирайте пролиті рідини;
- встановіть температуру в холодильнику на +2…+4 °C, у морозильнику — не вище –18 °C;
- пийте лише кип’ячену або бутильовану воду, уникайте вживання води з відкритих водойм;
- захищайте приміщення з продуктами від гризунів і комах;
- мийте руки з милом після контакту з тваринами.
Якщо помічаєте якісь симптом, то необхідно звернутися до сімейного лікаря та пройти обстеження в лабораторіях ДУ «Дніпропетровський ОЦКПХ МОЗ».
Джерело: 056.ua